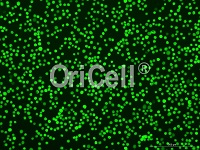

细胞特性及功能实验

血管形成实验
血管形成实验是测量在体外血管生成的一种快速的、可量化的方法。

平板克隆形成
克隆形成实验是测定细胞存活率和考察单个细胞增殖能力的有效方法之一

细胞划痕实验
细胞划痕实验是一种简易的检测细胞运动的方法,可以用来检测贴壁生长肿瘤细胞的迁移转移能力。

CCK-8实验
通过CCK-8检测细胞的增殖情况,掌握细胞生长状态。

EdU细胞增殖实验
通过检测细胞中遗传物质DNA的合成判断细胞的增殖状态。

细胞周期检测实验
通过流式细胞仪检测荧光强度,从而判断细胞处于哪一时期。

细胞凋亡Annexin V/PI双染实验
通过Annexin V及PI荧光双染的方法将凋亡早晚期的细胞以及死细胞区分开来。
实验原理
Annexin V是一种分子量为35~36KD的Ca2+依赖性磷脂结合蛋白,能与磷脂酰

Transwell侵袭实验
Transwell是细胞迁移的常用检测方法,细胞迁移也称为细胞爬行、细胞移动或细胞运动,是指细胞在接收到迁移信或感受到某些物质的梯度后而产生的移动。

β-半乳糖苷酶染色
衰老相关β-半乳糖苷酶的检测是有效检测细胞衰老的经典方法。
活性氧检测实验
通过DCFH-DA探针方法检测细胞中活性氧水平。

线粒体膜电位检测实验
通过JC-1探针检测方法监测细胞内线粒体膜电位的变化水平。